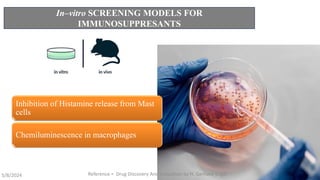
In–vitro SCREENING MODELS FOR
IMMUNOSUPPRESANTS
Inhibition of Histamine release from Mast
cells
Chemiluminescence in macrophages
5/8/2024 Reference = Drug Discovery And Evaluation by H. Gerhard Vogal 16

The document discusses immunosuppressants, their mechanisms, and applications, particularly in preventing organ rejection and treating autoimmune disorders. It details various in-vivo and in-vitro preclinical screening models for evaluating immunosuppressive agents, including methods using different animal models and specific tests. Additionally, it highlights the differences between in-vivo, in-vitro, and ex-vivo techniques in pharmacological studies.